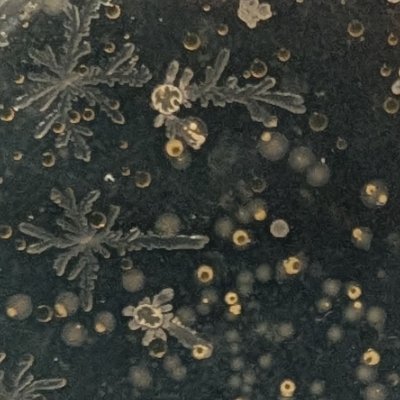
@qVNRIcOpKI15201

*:・謝bi’an *ੈ 🪽
@lucidspirall
Followers
238
Following
14K
Media
82
Statuses
1K
21oO𓆞 | 謝范 咎安📿🌊 ˖°𓇼⋆࿔*:・𝄞♫⋆。
hk|cn•he/she
Joined June 2022
I’m not seeing nearly as many vintage mermaids as vintage ballet, but it could just be me not looking in the right places.
12
220
2K
jolly patty but her nose didn't come out as planned so i covered it😢
2
11
21
Cinderella / Snow White.
5
3K
16K
do u think anybody be willing to comm me in exchange for a fortnite shop skin bundle
1
0
3